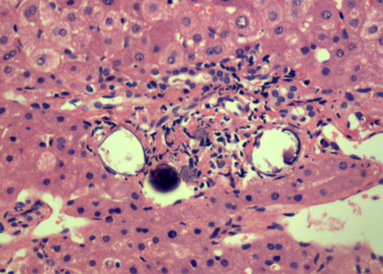
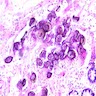

Table of Contents
Definition / general | Essential features | Terminology | ICD coding | Epidemiology | Sites | Pathophysiology | Etiology | Clinical features | Diagnosis | Laboratory | Radiology description | Radiology images | Prognostic factors | Case reports | Treatment | Gross description | Microscopic (histologic) description | Microscopic (histologic) images | Positive stains | Negative stains | Molecular / cytogenetics description | Differential diagnosis | Practice question #1 | Practice answer #1Cite this page: Bansal N. Schistosomiasis. PathologyOutlines.com website. https://www.pathologyoutlines.com/topic/colonschistosomiasis.html. Accessed September 30th, 2025.
Definition / general
- Schistosomiasis is a parasitic infection caused by a trematode blood fluke (WHO: Schistosomiasis [16 July 2018])
- First identified by Theodor Bilharz in 1852, also known as "bilharziasis"
- 5 different species: 3 major and 2 minor
- 3 major species include:
- Schistosoma mansoni
- S. japonicum
- S. haematobium
- 2 minor species include:
- S. mekongi
- S. intercalatum
- 3 major species include:
- Only S. haematobium causes genitourinary tract disease; all other species affect intestine and liver
Essential features
- Prevalence of disease highest in sub-Saharan Africa
Terminology
- Bilharziasis
- Snail fever
ICD coding
- ICD-10: B65.1 - Schistosomiasis due to Schistosoma mansoni [intestinal schistosomiasis]
Epidemiology
- Most patients are ages 15 - 20 years (J Med Case Rep 2014;8:331)
- Prevalence of schistosomiasis is highest in sub-Saharan Africa (Lancet 2012;380:2163)
- There are three major species (J Adv Res 2013;4:445)
- Schistosoma mansoni: Africa, South America, Middle East
- S. japonicum: Southeast Asia
- S. haematobium: Africa, Middle Eastern
Sites
- Liver, intestine, bladder, lungs, spleen, brain or spinal cord; less common sites of embolization include the skin and peritoneal surfaces
Pathophysiology
- Freshwater gets contaminated through feces (S. mansoni and S. japonicum) or urine (S. haematobium) from an infected person (Acta Trop 2000;77:41)
- In water, eggs release miracidia, which enter freshwater snails, the intermediate hosts
- Within snails, cercariae are formed and are released into the water after about four to six weeks
- Cercariae can survive in water up to two days
- Individuals become infected when skin contacts contaminated water and is penetrated by cercariae, which drop their tail and form schistosomulae
- Schistosomulae enter the circulation and reach the liver, where they mature into adults over two to four weeks
- Adult worms migrate against portal blood flow to the mesenteric venules of the small and large intestine (S. japonicum and S. mekongi), the mesenteric venules of the colon (S. mansoni, S. intercalatum) or the vesical venous plexus (S. haematobium)
- Migrating eggs elicit a host immune response
- Egg derived antigens induce a host Th2 immune response, leading to recruitment of eosinophils, granulomatous reaction and later fibrosis (Immunol Rev 2004;201:156, Immunol Cell Biol 2007;85:148, Front Immunol 2013;4:89)
Etiology
- Blood fluke, schistosomiasis
Clinical features
- Can be acute or chronic
- Acute occurs in travelers of nonendemic region
- Chronic disease occurs in individuals living in endemic regions
- Acute manifestations include swimmer's itch and Katayama fever
- Swimmer's itch causes itchy rash after swimming in water due to localized dermatitis
- Katayama fever
- Acute systemic hypersensitivity reaction to parasitic antigens and circulating immune complexes
- Inflammation of bowel causes ulceration, blood loss and scarring
- Within liver causes periportal fibrosis (or Symmers pipestem fibrosis) which can cause portal hypertension
- Chronic disease occurs in endemic areas usually three to eight weeks after infection; can present as diarrhea, chronic or intermittent abdominal pain, poor appetite (World J Surg Oncol 2010;8:68)
- Chronic colonic ulceration may lead to intestinal bleeding and iron deficiency anemia, intestinal polyps, dysplasia, bowel obstruction or acute appendicitis (Case Rep Infect Dis 2012;2012:896820)
Diagnosis
- Based on two types of tests: direct assay and indirect assay
- Direct assay is either the demonstration of eggs in the stool or urine or demonstration of antigen or DNA of parasite in the blood, urine or stool
- Circulating anodic antigen (CAA) and circulating cathodic antigen (CCA) excreted in urine are identified in antigen test (Lancet 2006;368:1106)
- Indirect assay is the demonstration of antibody to parasite in blood via serology
- Direct assay is either the demonstration of eggs in the stool or urine or demonstration of antigen or DNA of parasite in the blood, urine or stool
- Intensity of intestinal infection is classified as light (up to 100 eggs per gram), moderate (100 to 400 eggs per gram) or severe ( > 400 eggs per gram) (World Health Organization 2002:912)
- Most useful tests for returned travelers is serology
- Most useful test for individuals living in endemic areas is determining the parasite burden by microscopy for egg detection and antigen detection
Laboratory
- Egg identification in stool or urine by microscopy
- Eosinophilia, anemia, thrombocytopenia
Radiology description
- Colonoscopy can show congested mucosa / greyish yellow nodules / ulceration / polyps
- USG shows periportal fibrosis in hepatic schistosomiasis
- Grading of thickness of periportal fibrosis on ultrasonography (Am J Trop Med Hyg 1992;46:403)
- Grade I: 3 - 5 mm
- Grade II: 5 - 7 mm
- Grade III: more than 7 mm
Radiology images
Prognostic factors
- The adult worms live for 5 - 7 years but can remain in tissue for up to 30 years
- Embolization of adult worms into the spinal cord or cerebral blood vessels can cause neuroschistosomiasis
Case reports
- 20 year old Ethiopian woman with nonspecific abdominal symptoms (J Med Case Rep 2014;8:331)
- 51 year old woman with a past history of hypertension and dyslipidemia (J Community Hosp Intern Med Perspect 2016;6:33114)
Treatment
- Drug of choice is praziquantel, 40 - 60 mg/kg for at least four to six weeks (Clin Infect Dis 2009;48:1163)
Gross description
- Acute schistosomiasis: colonic mucosa is edematous and congested with petechial hemorrhage
- Chronic schistosomiasis: colonic mucosa has flat or elevated yellow nodules with vessels on surface, polyps and intestinal stricture
- The most characteristic finding is the grayish yellow or yellowish white schistosomal nodules which mimics antibiotic associated / pseudomembranous enterocolitis (World J Gastroenterol 2010;16:723)
Microscopic (histologic) description
- Ova are mainly seen in the loose submucosa of large intestine, usually with formation of granulomas and infiltration by eosinophils and inflammatory cells
- Later the muscularis mucosa becomes involved and the overlying mucosa shows small superficial ulcers
- Fibrosis develops in chronic stage, when only calcified eggs are seen
Microscopic (histologic) images
Contributed by Nalini Bansal Gupta, M.D., Lisa Cerilli, M.D. and @zaalruwai83 on Twitter
Images hosted on other servers:
S. japonicum:
Within tissue - species not specified:
Positive stains
- Ziehl-Neelsen:Schistosoma mansoni egg shells are ZN positive (Am J Trop Med Hyg 1954;3:1066)
Negative stains
- PAS stain
- Ziehl-Neelsen: Schistosoma haematobium shell is ZN negative
Molecular / cytogenetics description
- PCR for detecting free circulating DNA (Parasitol Res 2012;111:475)
- Cell free parasite DNA (CFPD) by PCR done on plasma for any stage of schistosomiasis (PLoS Negl Trop Dis 2009;3:e422)
Differential diagnosis
- Antibiotic associated colitis: due to formation of greyish yellow nodules on colonoscopy; parasitic eggs not seen
Practice question #1
- How does the schistosomiasis parasite involve the intestines and bladder?
- How do humans acquire schistosomiasis infections?
- What type of parasite is schistosomiasis?
- What is the other name for schistosomiasis?
- Which species of schistosomiasis affects the urinary bladder?
Practice answer #1
- By retrograde movement from portal vein to mesenteric vessels
- By swimming / contact with contaminated water
- Blood fluke
- Bilharziasis
- S. haematobium
Comment Here
Reference: Schistosomiasis